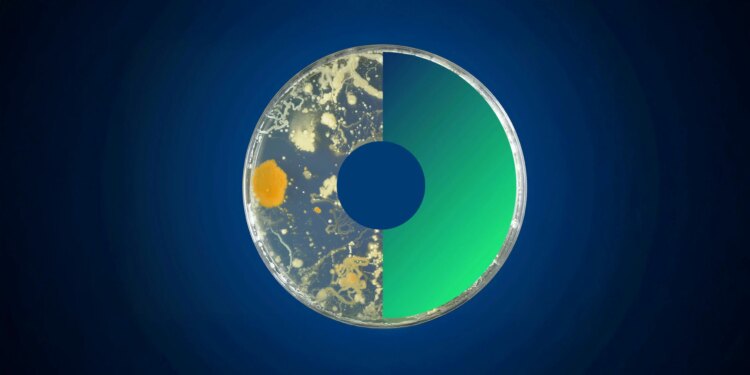

Foi anunciado o lançamento do 1.º concurso da Parceria Europeia cofinanciada “One Health – Antimicrobial Resistance” (EUP OHAMR), que contará com a participação da Fundação para a Ciência e a Tecnologia (FCT) como entidade financiadora nacional. As inscrições estão abertas até o dia 02 de fevereiro de 2026, às 12h00, horário de Portugal Continental.
Este concurso tem como objetivo apoiar projetos transnacionais de investigação e inovação, enfocando o tema “Novos Tratamentos para Enfrentar a Resistência Antimicrobiana”. Os projetos podem abordar diversos tópicos, incluindo a identificação e desenvolvimento de novos tratamentos combinados que utilizem antimicrobianos existentes ou inovadores, bem como a combinação destes com tratamentos complementares, visando aumentar a eficácia dos medicamentos e enfrentar a resistência.
Outra área de foco é o desenvolvimento de ferramentas e métodos que melhorem a adesão aos protocolos de tratamento, além de avaliar o impacto do uso de antimicrobianos na medicina veterinária e na agricultura, especialmente em relação ao risco de transmissão da resistência para seres humanos e para o ambiente. Essa avaliação buscará informar políticas que limitem o uso de certos antimicrobianos na medicina humana.
Os interessados em participar podem encontrar mais detalhes deste concurso na página da FCT e no site da EUP OHAMR. A Parceria EUP OHAMR, financiada pelo Programa-Quadro Horizonte Europa, busca promover a colaboração entre agências de financiamento do Espaço Europeu de Investigação, com ênfase em projetos conjuntos de pesquisa e inovação em áreas prioritárias relacionadas à Resistência Antimicrobiana, sob a perspectiva de Uma Só Saúde. Este consórcio inclui 53 organizações de 30 países, com a participação de Portugal representada pela FCT e pela Agência de Investigação Clínica e Inovação Biomédica (AICIB).
Origem: Fundação para a Ciência e a Tecnologia